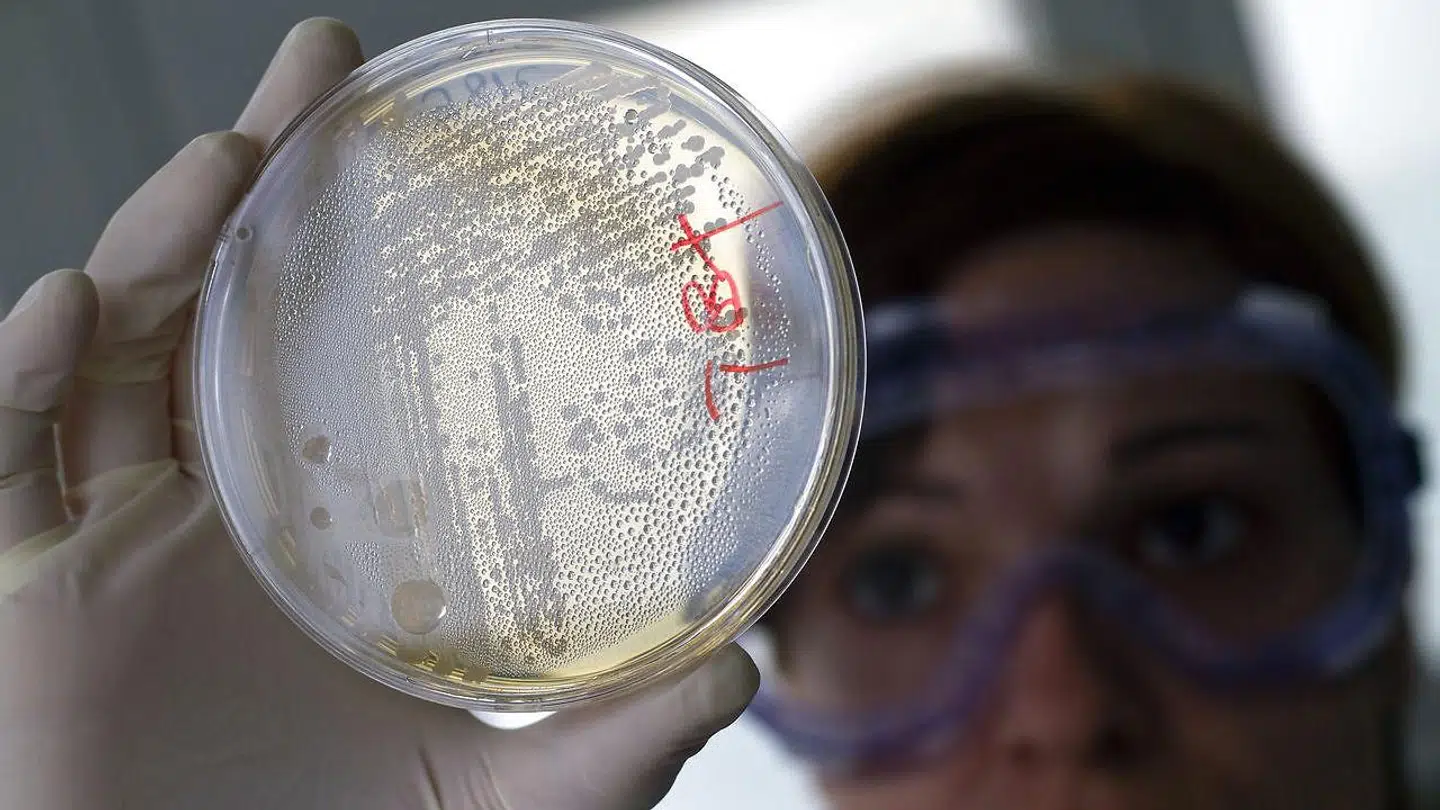
Arkivfoto. Foto: REUTERS/Francisco Bonilla
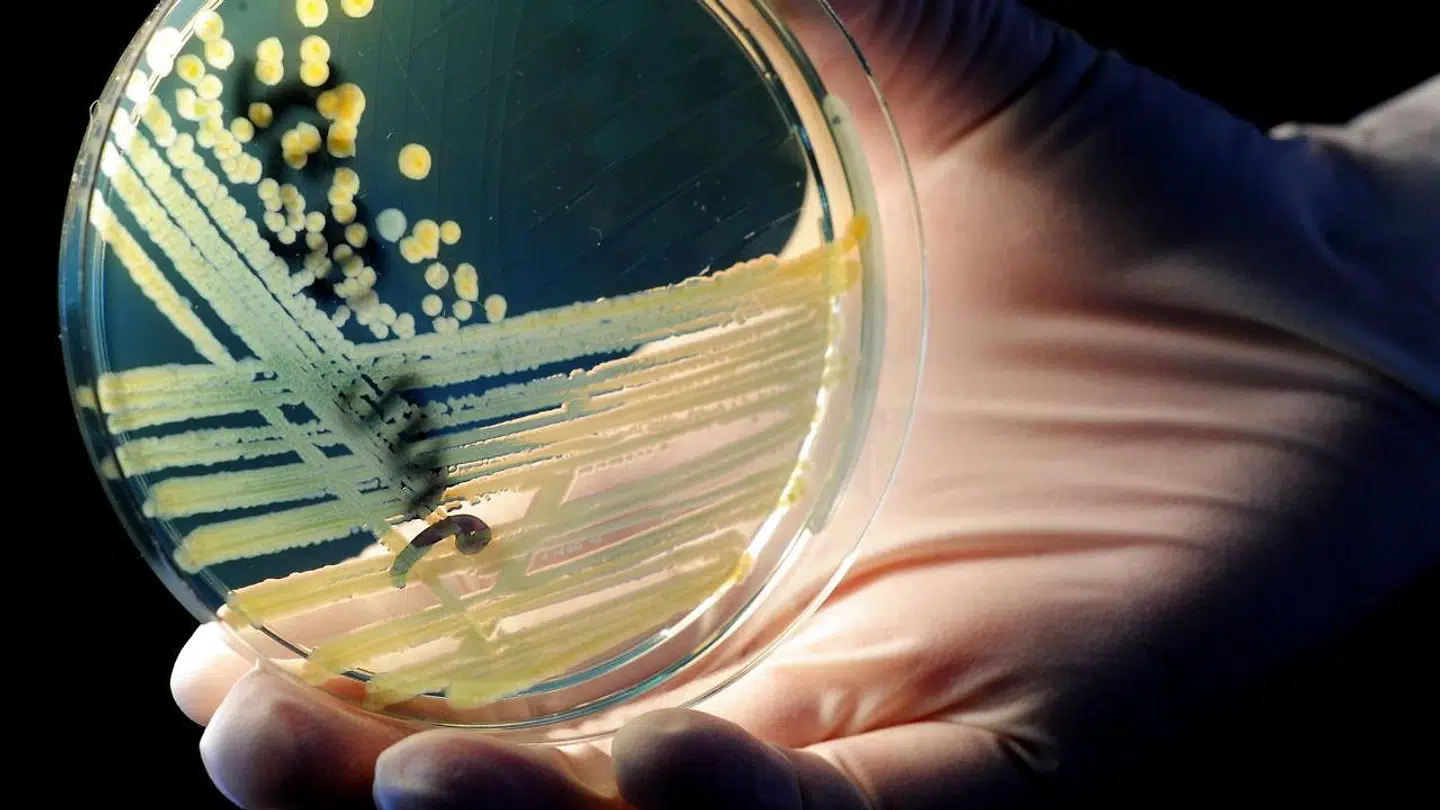

»40 til 50 procent dør, hvis de bliver smittet, og antibiotika hjælper ikke.«
Sådan fortæller læge og forskerleder ved virksomheden Sani Nudge, Marco Bo Hansen, om svampen med navnet 'candida auris'. En svamp, som han har kendskab til gennem sit arbejde.
Og netop candida auris skal man holde øje med, da den har bredt sig til 123 personer i USA i løbet 2021 og har kostet tre af de smittede personer livet.
Den blev opdaget tilbage i Japan i 2009, hvor den frem til 2020 har ramt 4.733 personer i 33 forskellige lande. Heraf er næsten halvdelen døde af infektionen.
Norge og Tyskland har haft få tilfælde af infektionen, men svampen er endnu ikke nået til Danmark.
Svampen sætter sig i vægge og lofter og smitter på den måde mennesker, og hverken rengøringsmidler eller medicin virker mod den.Marco Bo Hansen, læge og forskningsleder, Sani Nudge
»Der har endnu ikke været nogle tilfælde i Danmark, da vi har høje testkrav og poder folk fra områder, hvor der er stor sandsynlighed for at få den,« siger Marco Bo Hansen og fortsætter:
»Men sandsynligheden for at den kommer til Danmark, er stor. Spørgsmålet er bare hvornår.«
En stor faktor, der spiller ind i spørgsmålet om, hvorfor den endnu ikke har været på visit i Danmark, er den igangværende pandemi, hvis man spørger forskeren.
Den har nemlig for en kort stund sat en stopper for den ellers store globale rejseaktivitet, der kan være med til at sprede infektionen vidt og bredt.

Men da restriktionerne verden over bliver løsnet stille og roligt, er risikoen for, at candida auris kommer til Danmark igen forøget. Og hvis den kommer til landet, vil den ikke være lige til at slippe af med igen.
Udover en større rejseaktivitet kan supersygehuse også være med til at sprede candida auris.
»Når patienter flytter sig fra et sygehus til et andet, kan det øge mængden af multiresistente bakterier herunder candida auris,« siger Marco Bo Hansen.
»Svampen sætter sig i vægge og lofter og smitter på den måde mennesker. Hverken rengøringsmidler eller medicin virker mod den. På et sygehus i Madrid kæmpede de med svampen i to år, før de kom af med den.«
Selvom det er skræmmende læsning, at en dødelig svampeinfektion kan komme til Danmark, er det ikke alle, der vil opleve symptomer eller blive syge af den.
»Hvis man er sund og rask, så er svampen ikke farlig. Men man skal bare være bevidst om, at den findes.«
Dog skal ældre eller folk med lavt immunforsvar være opmærksomme på sygdommen. Det samme gælder spædbørn, der generelt ikke skal eksponeres for svampeinfektioner.
Disse grupper er nemlig ekstra udsatte, når det kommer til candida auris.
Dog er symptomerne ikke lige til at få øje på.
Derfor lyder rådet at ringe til egen læge, hvis man har feber eller bliver dårlig. For så kan man blive testet for svampen candida auris.